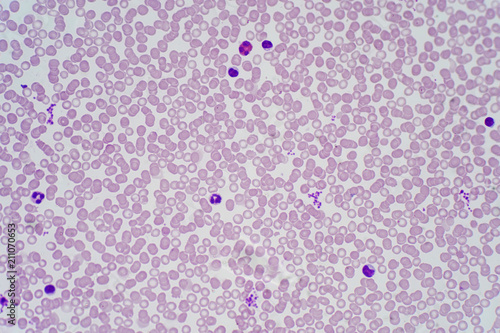

Home ⇨ Blood cells under microscope
Blood Cells Under Microscope
Get Blood cells under microscope For Android - Check out this fantastic collection of Best HD wallpapers, with the Best HD background images for your desktop, phone or tablet. Today i will share Blood cells under microscope wallpaper. From removable abstract wall murals to unique wallpaper with designs you have never seen before, these are the best places to buy trendy home.

Get Blood cells under microscope Free HD

:max_bytes(150000):strip_icc()/iStock_000070156299_Large-56ce88f75f9b5879cc62ea61.jpg)




















.jpg)
















